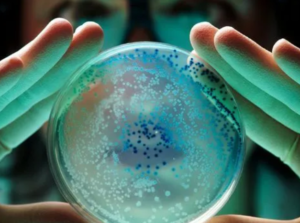

Les virologues ont « recouru à des pratiques anti-scientifiques pour faire va-loir leurs revendications »
La prise de conscience du caractère frauduleux de « toute la situation covid » au début de l’année 2020 a conduit les médecins Sam et Mark Bailey à effectuer une « plongée en profondeur » et à réaliser que la fraude autour de la virologie existait en fait depuis plus d’un siècle. Le couple avait été formé dans le système médical conventionnel, avait des croyances conventionnelles et pensait tout savoir sur la microbiologie et les germes. Cependant, comme les choses ne collaient pas à l’ère covid, ils ont entamé des recherches approfondies qui ont abouti à la publication de leurs propres livres – comme « The Final Pandemic – An antidote to medical tyranny » – et d’articles qui, selon Mark Bailey, expliquent pourquoi le modèle viral est « complètement frauduleux » et pourquoi les pandémies virales ne sont pas « une réalité ».

Selon les médecins Bailey, ils ont passé les quatre dernières années avec leurs alliés à démonter tous les aspects du modèle viral, qu’il s’agisse de l’« isolement », des anticorps, de la génomique, de la PCR, de la protéomique, de la microscopie électronique ou des études sur les animaux et les humains. En outre, lors de récents webinaires, le Dr Mark Bailey a discuté avec le Dr Tom Cowan des concepts de variables indépendantes et d’expériences contrôlées, entre autres. Mark Bailey déclare : « Il est clair que les virologues ont eu recours à des pratiques anti-scientifiques pour faire valoir leurs diverses revendications, y compris la revendication fondamentale de l’existence des virus ».
Une rencontre limitée
Personne n’a été en mesure de « réfuter sérieusement » leur matériel qui n’a « laissé aucune pierre non retournée », a déclaré Mark Bailey à Gareth Icke lors d’une récente interview sur Ickonic, où il affirme également que « le laboratoire de Wuhan, qui a gagné la théorie de la fonction, n’est qu’un ” lieu de rencontre limité ” ».
Faux raisonnement apical…….
Mark Bailey a été motivé pour écrire un essai, dit-il (ci-dessous), « traitant spécifiquement de l’erreur logique apicale dans la technique de culture cellulaire – quelque chose qui a été remarqué auparavant mais qui n’a peut-être pas été formellement exprimé ».
Le Dr Mark écrit : « Les virologues ont affirmé qu’ils effectuaient des expériences de contrôle et les décrivent parfois comme des cultures ” faussement infectées “. Ces derniers mois, nous avons également été contactés par des membres de la communauté ” sans virus ” qui nous ont demandé si John Enders n’avait pas réalisé par inadvertance une expérience de contrôle dans son article de 1954 sur la rougeole. Le Dr Stefan Lanka a dénoncé l’absence d’expérience de contrôle dans cet article devant le tribunal régional supérieur de Stuttgart en 2016, et je fais d’autres commentaires à ce sujet dans la note 20 ».
La question centrale est que les virologues n’ont pas de variable indépendante et que leurs expériences ne peuvent pas rendre réelle une particule hypothétique. La technique de référence pour « l’isolement » ne peut pas déterminer la présence (ou l’existence) de virus, quelle que soit la manière dont ils essaient de la contrôler. Le paradigme créé dans les années 1940 pour maintenir la virologie en vie est mort à l’arrivée parce que la technique repose sur un sophisme de réification et des erreurs logiques qui disqualifient l’ensemble du processus comme étant scientifique.
**********
L’horizon de la virologie
par Mark J. Bailey
Depuis le début de l’année 2020, la virologie fait l’objet d’un examen minutieux. Cette situation a été précipitée par le début de l’ère covid-19, en particulier lorsque le directeur général de l’Organisation mondiale de la santé, le Dr.Tedros Adhanom Ghebreyesus, s’est exprimé devant les médias internationaux le 11 mars 2020 et a déclaré : « Le covid-19 peut être qualifié de pandémie ». Pour de nombreuses personnes, la fraude[1] de la prétendue pandémie a commencé à peu près à ce moment-là ou pendant les bouclages et les restrictions sévères de la liberté de mouvement et des droits civils qui ont suivi. Pour d’autres, la fraude a commencé en 2009, lorsque l’OMS a modifié la définition de « pandémie » et que les mots « avec un nombre énorme de décès et de maladies » ont soudainement été exclus de la définition existante
Nous avons souligné que, bien que les développements susmentionnés semblent frauduleux, ils n’étaient que de petites ramifications d’une fraude scientifique fondamentale connue sous le nom de « science virologique »[2],[3],[4],[5]. Ces petites ramifications peuvent être qualifiées d’aspects «en aval» qui deviennent logiquement redondants lorsque les prémisses sur lesquelles ils s’appuyaient se révèlent aujourd’hui inexistantes ou, à tout le moins, des hypothèses apparemment invérifiables.
Quelles sont donc les prétendues preuves scientifiques qui sous-tendent le concept de « pandémie », quelle que soit la nuance qu’on leur donne ? Et en quoi leur examen ultérieur disqualifie-t-il la virologie en tant que science ?
Selon l’encyclopédie en ligne Wikipedia, une pandémie est « une épidémie de maladie infectieuse qui s’est propagée dans une vaste région, par exemple sur plusieurs continents ou dans le monde entier, et qui touche un nombre important d’individus »[6]. Une épidémie est définie comme « la propagation rapide[7] d’une maladie à un grand nombre d’hôtes d’une population donnée dans un court laps de temps ». Une maladie infectieuse est une maladie qui implique « l’invasion des tissus par des agents pathogènes, leur multiplication et la réaction des tissus de l’hôte à l’agent infectieux et aux toxines qu’il produit »[8]. En outre, il est précisé qu’« une maladie infectieuse, également connue sous le nom de maladie transmissible ou de maladie contagieuse, est une maladie résultant d’une infection ».[9]
Ces prétendus « agents pathogènes » comprennent les virus, qui seraient des particules sub-microscopiques dotées de propriétés physiques et biologiques spécifiques, notamment la capacité de réplication et la capacité de se transmettre entre des organismes tels que l’homme pour provoquer une maladie. (Les arguments sur la question de savoir s’il s’agit de véritables micro-organismes, s’ils sont morts ou vivants, etc. sont des considérations plus en aval et sans conséquence par rapport à la question centrale de leur existence). Si de nombreuses personnes considèrent l’existence des virus comme un fait scientifique établi, il n’en va pas de même pour les virus, mon expérience montre que la plupart des gens, y compris dans le monde de la santé, n’ont pas d’idée précise de ce qu’est un virus, y compris dans le domaine de la santé, n’ont pas examiné d’un œil critique les preuves citées pour vérifier par eux-mêmes si les méthodologies utilisées peuvent être qualifiées de scientifiques. Par ailleurs, il est largement méconnu que les virus n’ont pas été découverts puis étudiés – ils ont été imaginés. La virologie s’est ensuite inventée sur la base de ces particules hypothétiques : ….… l’un des principaux problèmes de la virologie est qu’elle s’est inventée en tant que domaine avant d’avoir établi si les virus existaient réellement.
Elle a essayé de se justifier depuis le début : Dans ce cas, une particule virale n’a pas été observée en premier lieu et la théorie et la pathologie virales se sont développées par la suite. Les scientifiques du milieu et de la fin du XIXe siècle étaient préoccupés par l’identification d’entités pathogènes contagieuses imaginaires….… Le présupposé de l’époque était qu’il existait une très petite particule de germe susceptible d’expliquer la contagion. Ce qui est venu par la suite est apparu pour répondre à ce présupposé.[5]
Depuis plus d’un siècle, on assiste à une série de pratiques pseudo-scientifiques, notamment l’utilisation continue d’un sophisme de réification, c’est-à-dire le fait de supposer que les virus ont une existence physique, alors qu’ils restent une hypothèse, malgré le fait qu’ils restent une construction hypothétique. En d’autres termes, « l’erreur qui consiste à traiter quelque chose qui n’est pas concret, comme une idée, comme une chose concrète ».[10]
On peut démontrer que les virologues se sont mis des bâtons dans les roues et que le paradigme qu’ils ont créé les a pris au piège. Si la discipline de la virologie est considérée comme une branche des sciences naturelles, alors ses praticiens sont tributaires de la science et de la technologie, ses praticiens s’appuient sur des preuves empiriques obtenues par l’observation et l’expérimentation. Dans le cadre de la méthode scientifique, il est nécessaire de formuler une hypothèse (nécessairement falsifiable) et de la tester par des expériences. Les expériences en question doivent comporter une variable dépendante, c’est-à-dire une observation ou un effet qui dépend d’une variable indépendante. La variable indépendante est la cause supposée de cette observation ou de cet effet. Les expériences nécessitent également un « contrôle », c’est-à-dire la possibilité de comparer les variables et les conditions de manière à pouvoir observer les résultats lorsque l’on fait varier un facteur à la fois.
Il n’y a aucune excuse pour permettre aux virologues de s’écarter du domaine scientifique dans lequel ils prétendent opérer. Comme on l’a noté dans « L’adieu à la virologie » (édition pour experts), les virologues ne doivent pas s’écarter du domaine scientifique dans lequel ils prétendent travailler.
En 2008, la revue Infection and Immunity a publié un commentaire intitulé, « Descriptive Science » qui expliquait pourquoi « la recherche descriptive en elle-même est rarement concluante et peut simplement servir de point de départ pour orienter d’autres recherches. rarement concluante » et peut simplement servir de point de départ pour orienter d’autres d’autres recherches. Les auteurs soulignent que « la microbiologie et l’immunologie sont désormais des sciences expérimentales et que, par conséquent, les enquêteurs peuvent aller au-delà de la simple description des observations pour formuler des hypothèses et, ensuite, les appliquer à d’autres domaines puis réaliser des expériences pour les valider ou les réfuter ».[5]
Et c’est là que réside la chute totale de la virologie et du modèle viral lui-même. Une expérience et méthode scientifique et qui prétend démontrer l’existence d’un virus doit avoir un contrôle valide pour établir que les effets observés sont bien ceux d’un virus, Un contrôle valide pour établir que les effets observés sont le résultat du virus (la prétendue variable indépendante) et non d’autres facteurs.
Si les virologues tentent même de réaliser une expérience de contrôle dans les méthodes qu’ils affirment utiliser pour démontrer l’existence d’un virus, ils omettent souvent les détails concernant le groupe « infecté fictivement » dans leurs publications. La définition d’une infection factice est la suivante : ….…un groupe de contrôle dans les expériences scientifiques conçues pour évaluer les effets de l’infection virale sur les cellules ou les organismes. Dans un groupe de contrôle faussement infecté, les cellules ou les organismes sont traités dans les mêmes conditions et avec les mêmes réactifs que le groupe infecté, sauf qu’ils ne sont pas exposés au virus[11]. Contrôle utilisé dans les expériences d’infection. Deux spécimens sont utilisés : l’un est infecté par le virus/vecteur en question, l’autre est traité de la même manière, mais sans le virus.[12]
En d’autres termes, la seule différence pour le groupe de contrôle est une variable – le virus présumé. Cela peut être fait dans le cas de cellules bactériennes ou fongiques car il est possible de séparer ces cellules et délaisser le reste du matériel biologique dans l’échantillon.[13]
Il est donc contesté que les virologues eux-mêmes aient admis qu’une véritable expérience d’infection simulée est impossible, car ils ne peuvent apparemment pas isoler physiquement (et donc éliminer) des particules virales à partir d’échantillons provenant d’un organisme prétendument atteint d’une maladie « virale ». Ainsi[14], les seules expériences qu’ils peuvent éventuellement réaliser doivent se rabattre sur l’affirmation préalable selon laquelle les particules virales sont présentes dans un groupe et non dans l’autre « faussement infecté ». Il s’agit d’un sophisme logique sous la forme de petitio principii, également connu sous le nom de « se poser la question », dans la mesure où l’on prétend prouver une proposition tout en la considérant comme acquise.[15],[16]
Bien que nombre d’entre nous qui ont critiqué le modèle viral aient déjà noté ce problème, nous n’avons[17] peut-être pas été assez explicites en soulignant que la raison pour laquelle les virologues ont « négligé » d’effectuer des expériences de contrôle valables sur des cultures cellulaires est que, par définition, ils ne sont pas en mesure de le faire.[18]
Leur situation difficile va plus loin que les tentatives d’isoler physiquement les particules dérivées de la procédure de « culture » de virus hypothétiques au cours d’expériences in vitro est scientifiquement invalide en tant que méthodologie permettant d’établir l’existence de quelque chose car l’interprétation des résultats dépend entièrement de la présomption que ce « quelque chose » doit exister. Les effets cytopathiques (ECP) sont censés indiquer la présence de virus, mais ils ne peuvent être considérés que comme l’observation de cellules se décomposant dans un puits de test. Les ECP sont la variable dépendante de l’expérience, mais il est évident qu’aucune variable indépendante (un « virus ») ne peut être discernée dans ce processus. Le virus postulé reste hypothétique car il n’a pas pu être identifié comme une entité spécifique au début de la procédure et on ne peut donc pas prétendre qu’il a une existence physique en se basant uniquement sur des observations ultérieures impliquant la variable dépendante.

À ce stade, on peut affirmer que l’apparition in vitro de nanoparticules vésiculaires dans une culture cellulaire mélangée à un spécimen dérivé d’un virus reste hypothétique. Que la culture cellulaire mélangée à un échantillon dérivé d’un organisme atteint d’une maladie « virale » fournit la preuve que les virus existent. Cependant, ceci invoque une fois de plus le sophisme petitio principii mentionné plus haut, puisque l’existence d’un virus (et nombre de ses propriétés supposées) est affirmée à l’avance sous la forme d’une maladie « virale ».
Nous pouvons résumer que certains des problèmes liés à l’utilisation de cultures cellulaires en tant que prétendues preuves sont les suivants :
(a) Les particules déclarées « virales » sont observées pour la première fois dans le cadre des observations de l’ECP c’est-à-dire qu’elles sont des variables dépendantes. Il est absurde de prétendre qu’elles sont également la variable indépendante dans la même expérience.[19]
(b) Les observations in vitro (en laboratoire) ne peuvent pas être considérées comme reproduisant un processus in vivo (à l’intérieur de la vie).[20]
(c) Les techniques utilisées en microscopie électronique introduisent d’autres variables qui ne sont pas contrôlées, en plus de l’artefact technique et de la limitation supplémentaire qu’il s’agit de structures statiques encastrées dans de la résine et non de structures vivantes.[21],[22]
Les détails de chaque expérience de culture cellulaire publiée peuvent être analysés en profondeur, ce qui a été fait par nous et par d’autres à de nombreuses occasions. En eux-mêmes, les points (b) et (c) soulèvent des problèmes actuellement insurmontables, car il n’est pas clair si les observations dans ces contextes reproduisent la biologie naturelle. Quoi qu’il en soit, l’ensemble du processus repose sur un sophisme logique, dont une manifestation est exprimée au point (a) et qui, en ce qui concerne la question cruciale de l’existence du virus, rend l’ensemble de l’exercice invalide.
Il faut garder à l’esprit que la technique de culture cellulaire est l’étalon-or de la virologie et qu’elle a été utilisée pour établir le modèle viral postulé. On ne sait pas si l’un des praticiens s’est rendu compte que la méthodologie qu’il a employée ne pouvait pas être contrôlée scientifiquement. Le principe fondamental de la définition du virus est que les particules pathogènes provoquent des répliques chez l’hôte, mais que les cultures cellulaires « étalon-or » établies ne peuvent pas déterminer leur existence – l’information est au-delà de l’« horizon des événements » de la technique. De l’avis général, il n’y a plus rien à quoi se raccrocher et il est impossible de s’échapper d’un paradigme aussi redondant.
Les virologues peuvent protester que ces techniques sont les seules dont ils disposent parce qu’il n’est pas possible d’obtenir les virus supposés directement à partir d’êtres humains vivants ou d’autres organismes, ce qu’ils ont un jour cherché à faire mais qu’ils ont apparemment abandonné. Une telle protestation n’a aucune valeur scientifique et la charge de la preuve reste sur leurs épaules. Les tentatives d’étayer le modèle viral par des méthodes scientifiques ont clairement échoué et les virus imaginés n’ont pas d’existence connue en dehors de sophismes logiques et d’affirmations pseudo-scientifiques.[23]
La citation d’observations indirectes telles que les conditions cliniques, les groupes apparents de maladies, les dosages d’anticorps, la génomique, la protéomique et les tests tels que la réaction en chaîne de la polymérase ne peuvent constituer une preuve de l’existence de virus, car le demandeur s’engage dans une boucle de raisonnement circulaire dans laquelle il a déjà supposé l’existence d’un virus. Aucune de ces observations ne peut fournir les preuves nécessaires à la vérification du modèle viral. Le péché originel est l’erreur de réification.
Malheureusement pour l’humanité, l’imagination des virologues au sujet de leurs particules s’est répandue dans suffisamment d’esprits pour mettre le monde à genoux en 2020. Une pétoire a été créée, mais qui va-t-elle finalement hisser ?[24]
Car c’est le sport de voir l’ingénieur de se faire hisser par sa propre pétoire, et cela va durer.[25]
Notes :
- Ghebreyesus, T., « WHO Director-General’s opening remarks at the media briefing on covid-19 – 111 March 2020 », 11 Mar 2020
https://www.who.int/who-director-general-s-opening-remarks-at-the-media-briefing-on-covid-19-11-march-2020 (archived) - Law, R., « WHO and the pandemic flu ´conspiracies´ », 6 Jun 2020
https://www.researchgate.net/WHO-and-the-pandemic-flu-conspiracies - Engelbrecht, T., et al., « Virus Mania », 3rd English Edition
- Bailey, M. & Bevan-Smith, J., « The covid-19 Fraud & War on Humanity », 11 Nov 2021
https://drsambailey.com/the-covid-19-fraud-war-on-humanity - Bailey, M., « A Farewell to Virology » (Expert Edition), 15 Sep 2022
https://drsambailey.com/a-farewell-to-virology-expert-edition - « Pandemic », Wikipedia https://en.wikipedia.org/wiki/Pandemic (accessed 10 Mar 2024)
- « Epidemic », Wikipedia https://en.wikipedia.org/wiki/Epidemic (accessed 10 Mar 2024)
- « Infection », Wikipedia https://en.wikipedia.org/wiki/Infection (accessed 10 Mar 2024)
- « Reification (fallacy) », Wikipedia https://en.wikipedia.org/wiki/Reification_(fallacy) (accessed 10 Mar 2024)
- « mock-infected », GenScript https://www.genscript.com/biology-glossary/10558/mock-infected
- « mock-infected », North Western University https://groups.molbiosci.northwestern.edu/holmgren/Glossary/Definitions/Def-M/mock-infected.html
- Rien ne prouve que les micro-organismes en tant que tels aient la capacité « pathogène » d’envahir des tissus sains et de provoquer des maladies.
https://drsambailey.com/germ-theory/why-pathogens-dont-exist
Cependant, des expériences avec des contrôles valides sont possibles avec des cellules bactériennes et fongiques, de sorte que l’hypothèse peut être testée.
- Le 23 mars 2024, la biostatisticienne Christine Massey a rassemblé les réponses officielles de 222 institutions médicales et scientifiques confirmant qu’il n’existe aucune preuve de la présence du prétendu virus « SRAS-CoV-2 » chez l’homme.
https://www.fluoridefreepeel.ca/fois-reveal-that-health-science-institutions-around-the-world-have-no-record-of-sars-cov-2-isolation-purification (accessed 30 Mar 2024) - Welton, J., « A manual of logic », Volume 2, 1905 : « Petitio principii is, therefore, committed when a proposition which requires proof is assumed without proof ».
https://archive.org/details/amanuallogicvol00weltgoog/page/n298/mode/2up - Il y a en fait deux cas où l’erreur de petitio principii est commise au cours du processus de culture cellulaire : le premier est que des virus sont présents dans l’échantillon « maladie virale » et le second est qu’aucun virus n’est présent dans l’échantillon « infecté fictif ». Cet essai explique pourquoi la technique de la culture cellulaire ne permet pas de déterminer si un virus est présent ou non.
- Cowan, T., et al., « The ‘Settling The Virus Debate’ Statement », 14 Jul 2022
https://drsambailey.com/settling-the-virus-debate/ - Les détracteurs de la technique de culture cellulaire ont affirmé que des expériences de contrôle ont parfois été réalisées et qu’elles ont également produit des effets cytopathiques, ce qui a permis de réfuter l’expérience des virologues. (Par exemple, dans cette vidéo qui analyse l’article de John Enders de 1954 intitulé « Cytopathogenic Agents from Measles Cases » (Agents cytopathogènes provenant de cas de rougeole), @1.18.25
https://odysee.com/@spacebusters:c9/Final-The-End-of-Germ-Theory:8
Toutefois, l’analyse ne tient pas compte de la définition correcte de l’expression « infection simulée ». Pour être correctement contrôlé dans ce contexte, il faut manipuler une variable indépendante (l’« agent cytopathogène » ou « virus »), ce que les virologues sont incapables de faire, comme le souligne cet essai. La présence ou l’absence de la maladie de la rougeole chez un patient n’est pas une variable indépendante dans l’expérience de laboratoire. En outre, Enders a indiqué dans l’article de 1954 qu’« un deuxième agent a été obtenu à partir d’une culture non inoculée de cellules rénales de singe », ce qui implique qu’un « virus » différent était déjà présent dans la lignée cellulaire ou qu’il avait contaminé cette culture particulière. Ce « virus » produirait des effets cytopathiques distincts : lorsque les cellules des cultures infectées ont été fixées et colorées, leur effet a pu être facilement distingué car les changements inter-nucléaires typiques des agents de la rougeole n’ont pas été observés. Il n’a donc jamais été considéré comme un contrôle et la technique a pu être « maintenue » dans ces conditions. Bien qu’Enders ne dispose manifestement pas d’un contrôle valable (et qu’il ne le pouvait pas non plus), l’auteur reconnaît qu’il s’agit là d’une preuve supplémentaire contre l’utilité de la technique de culture cellulaire. Voir également la note 18 pour la faille logique fatale de la technique de culture cellulaire, quels que soient les résultats.
- Les virologues ont également échoué sur ce front : ils n’ont pas prouvé que des particules « purifiées » dérivées de cultures cellulaires puissent satisfaire aux postulats de Koch ou de Rivers en matière de pathogénicité. En outre, l’introduction de « L’identification des pathogènes microbiens basée sur la séquence » par Fredricks et Relman en 1997 ne peut pas être utilisée pour établir l’existence des virus et les auteurs eux-mêmes ont admis que, « avec seulement des séquences amplifiées disponibles, le rôle biologique ou même l’existence de ces micro-organismes présumés reste incertain ».
https://europepmc.org/backend/ptpmcrender.fcgi?accid=PMC172879&blobtype=pdf
Quoi qu’il en soit, la note 15 expose le problème fondamental : les postulats de Koch, formulés scientifiquement, n’ont jamais été démontrés pour aucun microbe, même ceux dont l’existence peut être démontrée.
https://drsambailey.com/germ-theory/kochs-postulates-germ-school-dropout
- Bailey, S., « Electron Microscopy and Unidentified ‘Viral’ Objects », 16 Feb 2022
https://drsambailey.com/covid-19/electron-microscopy-and-unidentified-viral-objects - Hillman, H., « Certainty & Uncertainty in Biochemical Techniques », Surrey University Press, U.K, 1972. For24 a summary see here :
https://www.big-lies.org/harold-hillman-biology/certainty-and-uncertainty-in-biochemical-techniques - Parmi les autres éléments contestables des techniques de culture cellulaire employées par les virologues, il y a la sélection de lignées cellulaires qui peuvent être : (a) sans rapport avec le type de cellule malade dans l’organisme, (b) chromosomiquement anormales, et (c) provenant d’une autre espèce. Dans un autre raisonnement circulaire, il est évident que ces cellules ont été choisies parce qu’elles ont une propension à réagir de la manière souhaitée par les virologues. Ce qui est fatal pour la technique, c’est qu’il a également été démontré que les ECP peuvent résulter du processus lui-même, sans introduction de spécimens externes.
https://drsambailey.com/a-farewell-to-virology-expert-edition - La présomption de maladies « virales » et de contagiosité fait partie d’un ensemble de souffrances induites par la conviction que les « germes » sont à l’origine des maladies. Cette histoire de croyances erronées est décrite dans « The Final Pandemic -An Antidote to Medical Tyranny », 2024, particularly chapters 2 and 3
https://drsambailey.com/the-final-pandemic - Shakespeare, W., « The Tragedy of Hamlet, Prince of Denmark », 1603
yogaesoteric
8 mai 2024